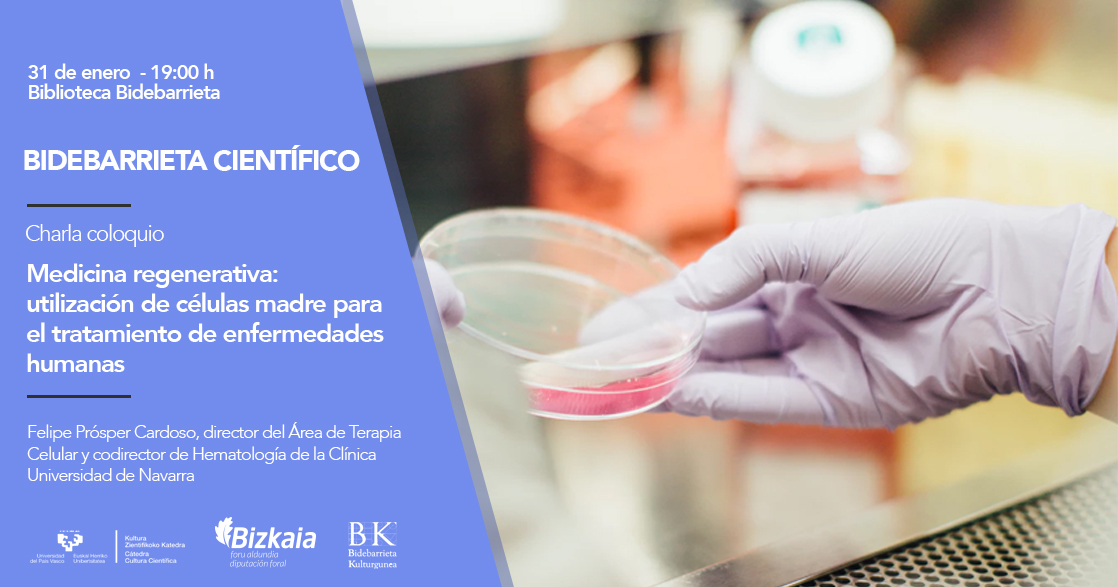

Conferencia: 'Medicina regenerativa: utilización de células madre para el tratamiento de enfermedades humanas'
- Evento
Cuándo y dónde
31/01/2018, 19:00 - 00:00
Lugar
Biblioteca de Bidebarrieta
Bidebarrieta 4. -48005- Bilbao (Bizkaia)
Descripción
Las investigaciones realizadas en los últimos veinte años han demostrado la capacidad de regeneración de los tejidos dañados asociada a la presencia de células madre específicas. Esta es precisamente la premisa sobre la que trabaja la medicina regenerativa y la terapia celular, basada en el uso de medicamentos de terapia avanzada para el tratamiento de ciertas enfermedades humanas.
Pero, ¿cuáles son los principios científicos que justifican la utilización de estos medicamentos y las dificultades regulatorias y científicas a las que hay que hacer frente para llevarlos a la práctica clínica? El doctor Felipe Prósper Cardoso, director del Área de Terapia Celular y codirector de Hematología de la Clínica Universidad de Navarra, abordará las realidades y los retos de futuro de las terapias celulares en una conferencia titulada “Medicina regenerativa: utilización de células madre para el tratamiento de enfermedades humanas”, que se celebrará el día 31 de enero, a las 19:00 de la tarde, en la Biblioteca Bidebarrieta de Bilbao (Calle Bidebarrieta, 4).
El doctor en Tecnología Farmacéutica en la UPV/EHU Gorka Orive se encargará de conducir esta charla que se enmarca dentro del ciclo “Bidebarrieta Científico” una iniciativa que organiza todos los meses la Cátedra de Cultura Científica de la UPV/EHU y la Biblioteca Bidebarrieta para divulgar asuntos científicos de actualidad.
Todas las charlas son de acceso libre y gratuito hasta completar el aforo. Los que no puedan acudir, podrán seguir las charlas vía streaming a través de este enlace.

